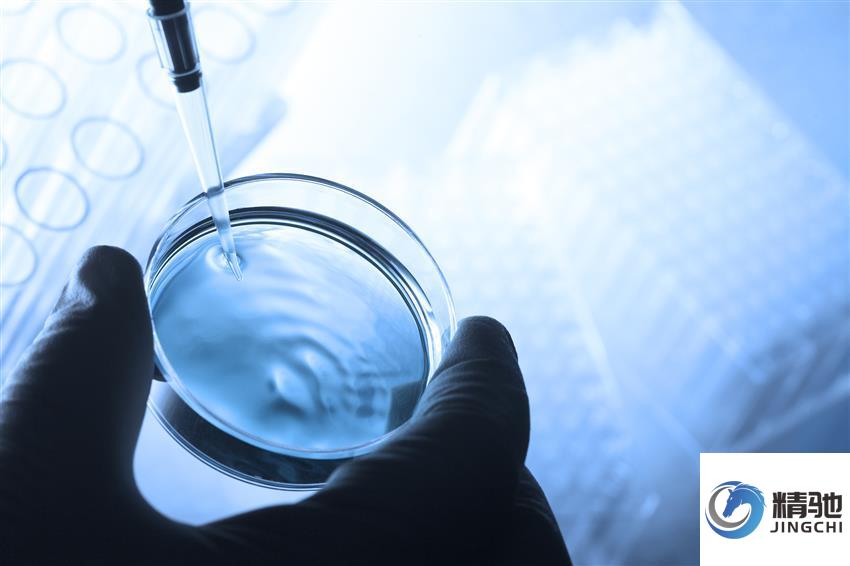
试验用药品:临床试验中最该被“较真”的那件事

最近有准备备案的医院老师问起:药物临床试验为什么要分I、II、III、IV期?每一期到底在做什么?这个问题看似基础,但确实值得细说。因为理解了分期的逻辑,也就理解了临床试验这个“系统工程”是怎么一步步把一个新药推向市场的。对准备建设临床试验机构的医院来说,了解这些,也能更清楚自己现阶段适合承接哪类项目。今天,我们就来简单梳理一下。一、I期:第一次在人体身上用I期试验是新药第一次

在临床试验的伦理审查中,有一个概念经常被提及,但未必每个人都真正理解它的分量——最小风险。它不是一个抽象的理论,而是一把实实在在的“尺子”。伦理委员会用它来衡量试验的风险是否可控,研究者用它来判断知情同意需要强调到什么程度,申办方用它来设计试验方案时平衡科学价值与受试者保护。今天,想和你聊聊这把“尺子”是怎么用的,以及它对医院临床试验机构意味着什么。一、什么是最小风险?按GCP

在临床试验的伦理审查中,有一个词,平时不太被提起,但一旦出现问题,往往是最难解释的——利益冲突。它不是指委员收了黑钱、做了坏事,而是一种更隐蔽、更普遍的情况:当委员与所审查的试验项目之间存在某种利益关系,这种关系可能影响他/她从保护受试者的角度出发,做出公正独立的判断。利益冲突不可怕,可怕的是不识别、不管理、不回避。今天,想和你聊聊这道伦理审查中的“红线”,以及医院在GCP备案

在临床试验的世界里,有一种特殊的“药”,它没有活性成分,吃下去不会对疾病产生任何治疗作用,但在试验设计中却扮演着不可或缺的角色——它就是安慰剂。对于没有接触过临床试验的人来说,这个词可能带着一点神秘色彩:为什么要让受试者吃“假药”?这公平吗?对于准备建设临床试验机构的医院来说,更现实的问题是:安慰剂从哪里来?怎么管?有什么特殊要求?今天,想和你聊聊这个“空白对照”背后的门道。一

在临床试验的语境里,有两个词,平时各说各的,很少被放在一起讨论——一个是设盲。它关乎“谁知道谁吃了什么药”,是保证试验结果客观性的经典设计。一个是计算机化系统验证。它关乎“电子系统记录的东西到底能不能信”,是数字化时代绕不开的技术门槛。但如果我问你:一个需要双盲设计的试验,用的是电子病历系统记录数据,系统本身有没有经过验证?系统里谁有权修改数据?修改会不会留下痕迹?——你会发现

在临床试验机构的备案准备中,有一项工作看起来最“实在”,也最容易让人摸不着头脑——试验现场的设施设备配置。实在,是因为它看得见摸得着;让人摸不着头脑,是因为不同医院、不同科室、不同项目,需要的东西似乎都不一样。GCP只提原则,不列清单,具体到每家医院,到底该配什么、配多少、配到什么程度,常常让人拿不准。今天,想和你聊聊这个“硬件”话题:临床试验机构和科室的现场,到底需要哪些设施

在临床试验的日常里,有一种很常见的尴尬:检查员来了,想看某份原始病历,但那本病历是医院的法定病案,按规定不能出病案室,更不能随便复印带走。或者,受试者的原始影像资料存在PACS系统里,监查员总不能抱着电脑去机房看。这时候,就需要一个东西出场——核证副本。它不是什么高深的发明,但它的存在,解决了一个很实际的问题:当原件不能动的时候,拿什么来证明“这就是真的”?今天,想和你聊聊这个

在临床试验的日常里,有一类文件,平时可能不太引人注意,但每次监查、每次核查,它都会被翻出来反复比对。它就是源文件。这个词听起来有点官方,其实说白了,就是“第一手记录”——那些在试验现场最初产生的、未经任何加工或转录的数据和文件。今天,想和你聊聊这个看似基础、却撑起整个临床试验数据真实性的“地基”。一、什么是源文件?按照GCP的说法,源文件是临床试验中产生的原始记录、文件和数据。

在临床试验的日常里,我们经常会遇到这样的情况:受试者说“有点头晕”,化验单上出现了一个异常的箭头,或者受试者因为感冒住了院。这些,我们都叫它“不良事件”。但其中有一类,需要研究者多问自己一个问题:这个事件,和试验用的药物有没有关系?如果答案是“可能有”,那么它就不再只是一个事件,而是一个需要被特别关注的信号——药物不良反应。今天,想和你聊聊这个“可能有关”背后的含义,以及它对临
在临床试验机构的工作里,有一个词,听起来平平无奇,却是整个研究的“心脏”——试验用药品。它不是一个抽象的概念,而是一盒盒贴着“仅用于临床试验”标签的药物,是受试者每天服下的那一粒胶囊,是研究者反复核对的那一行批号,是数据表上那一串无法重来的记录。今天,想和你聊聊这个最该被“较真”的东西。一、先分清两个词:试验药、对照药根据GCP的定义,试验用药品是一个“家族姓氏”,下面有两兄弟